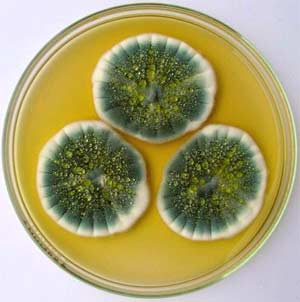

Khoảng 90 % kháng sinh tự nhiên đều được sản xuất
Khoảng 90 % kháng sinh tự nhiên đều được sản xuất từ
Đáp án đúng là: D
Quảng cáo
Sử dụng công nghệ vi sinh vật để sản xuất thuốc kháng sinh chữa bệnh cho người và động vật.
Đáp án cần chọn là: D
>> Học trực tuyến Lớp 10 cùng thầy cô giáo giỏi tại Tuyensinh247.com, (Xem ngay) Cam kết giúp học sinh học tốt, bứt phá điểm 9,10 chỉ sau 3 tháng, làm quen kiến thức, định hướng luyện thi TN THPT, ĐGNL, ĐGTD ngay từ lớp 10
![]() |
![]() |
![]() |
![]() |
![]() |
![]() |
![]() |
![]() |
Hỗ trợ - Hướng dẫn
-
024.7300.7989
-
1800.6947
(Thời gian hỗ trợ từ 7h đến 22h)
Email: lienhe@tuyensinh247.com












